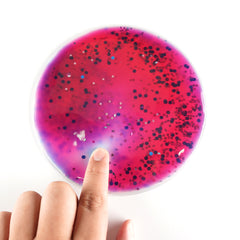

Product Description
The glitter and liquid filled sensory shapes for exploratory play. The sensory shapes are excellent for light boxes. Introduce basic maths and geometry with these gel filled shapes. Each squishy shape is filled with non toxic oil, water and colour. They also have glitter for some extra fun and sparkle! The square sensory shape measures 16cm wide. This set includes 6 pieces.










Related Products
From this Collection
-
Edusense Sensory Liquid Floor Tiles (6 PCS)$161.40 GBP
-
Edusense Gel Bead Math Educational Toys$33.99 GBP
-
Edusense Sensory Gel Bead Liquid Bag$35.99 GBP
-
Edusense Sensory Bottles$0.00 GBP
Loading
Loading
Error